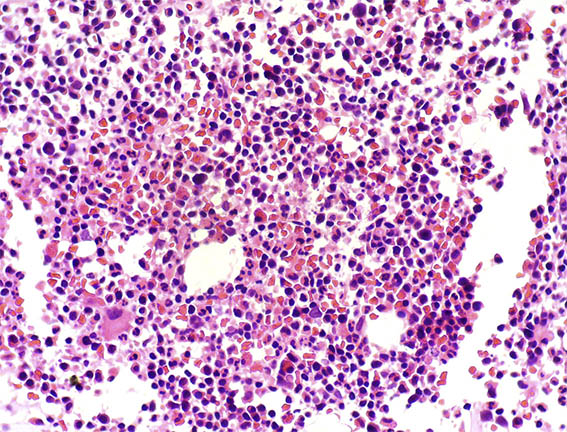

|
|
Go
back to clinical information and images
Diagnosis: Cast Nephropathy and Amyloidosis (AL lambda)
It is very inusual to find in a renal biopsy of patients with plasma cell proliferations, combination of filtered light chains in tubules (in this case causing cast nephropathy) and simultaneously deposition of paraproteins in tissues. This event is reported in approximately 2-5% of patients with renal disease due to plasma cell dyscrasias. The bone marrow biopsy demonstrated lambda positive multiple myeloma (Figures 13 and 14).
Figure 13. Bone marrow biopsy. H&E, X400.

Figure 14. Immunohistochemistry for kappa (left) and lambda (right) in bone marrow biopsy, demonstrating monoclonal plasma cells. X400.
See the chapter: Amyloidosis, Multiple Myeloma... of our Tutorial.
Go
back to clinical information and images
References
-
Leung N, Nasr SH. Myeloma-related kidney disease. Adv Chronic Kidney Dis. 2014;21(1):36-47. [ PubMed link]
-
Gnemmi V, Leleu X, Provot F, Moulonguet F, Buob D. Cast nephropathy and light-chain deposition disease in Waldenström macroglobulinemia. Am J Kidney Dis. 2012;60(3):487-91 [ PubMed link]
-
Nasr SH, Valeri AM, Sethi S, Fidler ME, Cornell LD, Gertz MA, Lacy M, Dispenzieri A, Rajkumar SV, Kyle RA, Leung N. Clinicopathologic correlations in multiple myeloma: a case series of 190 patients with kidney biopsies. Am J Kidney Dis. 2012;59(6):786-94. [ PubMed link]
-
Lorenz EC, Sethi S, Poshusta TL, Ramirez-Alvarado M, Kumar S, Lager DJ, Fervenza FC, Leung N. Renal failure due to combined cast nephropathy, amyloidosis and light-chain deposition disease. Nephrol Dial Transplant. 2010;25(4):1340-3. [ PubMed link]
-
Qian Q, Leung N, Theis JD, Dogan A, Sethi S. Coexistence of myeloma cast nephropathy, light chain deposition disease, and nonamyloid fibrils in a patient with multiple myeloma. Am J Kidney Dis. 2010;56(5):971-6. [ PubMed link]
-
Herrera GA, Joseph L, Gu X, Hough A, Barlogie B. Renal pathologic spectrum in an autopsy series of patients with plasma cell dyscrasia. Arch Pathol Lab Med. 2004;128(8):875-9. [ PubMed link]
[Top]
Go
back to clinical information and images |
|